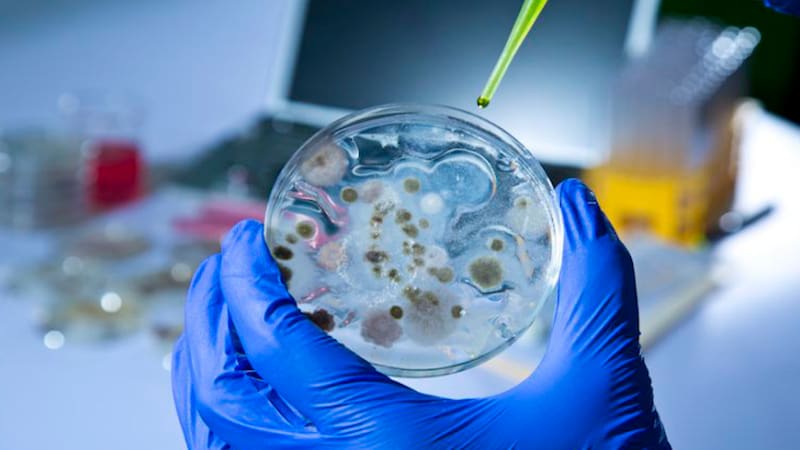

Identifican 70 enzimas capaces de devorar los residuos de la industria textil
A través de un proceso a bajo costo, científicos británicos lograron que un grupo de moléculas orgánicas deshicieran el poliéster, la fibra más utilizada en el mundo.
COMENTARIOS
Para comentar este artículo debes ser suscriptor.











